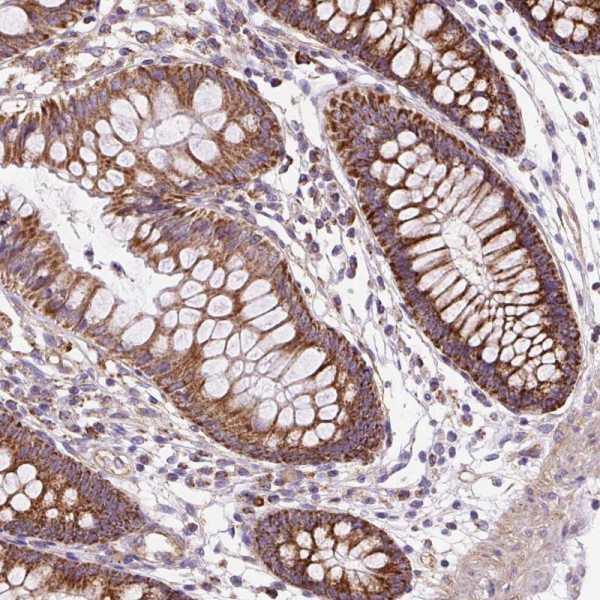
Anti-CEP290

Cookie preferences
This website uses cookies, which are necessary for the technical operation of the website and are always set. Other cookies, which increase the comfort when using this website, are used for direct advertising or to facilitate interaction with other websites and social networks, are only set with your consent.
Configuration
Technically required
These cookies are necessary for the basic functions of the shop.
"Allow all cookies" cookie
"Decline all cookies" cookie
CSRF token
Cookie preferences
Currency change
Customer-specific caching
FACT-Finder tracking
Individual prices
Selected shop
Session
Comfort functions
These cookies are used to make the shopping experience even more appealing, for example for the recognition of the visitor.
Note
Show the facebook fanpage in the right blod sidebar
Statistics & Tracking
Affiliate program
Conversion and usertracking via Google Tag Manager
Track device being used
| Item number | Size | Datasheet | Manual | SDS | Delivery time | Quantity | Price |
|---|---|---|---|---|---|---|---|
| ATA-HPA043918.25 | 25 µl | - |
7 - 10 business days* |
246.00€
|
|||
| ATA-HPA043918.100 | 100 µl | - |
7 - 10 business days* |
491.00€
|
If you have any questions, please use our Contact Form.
You can also order by e-mail: info@biomol.com
Larger quantity required? Request bulk
You can also order by e-mail: info@biomol.com
Larger quantity required? Request bulk
Protein function: Involved in early and late steps in cilia formation. Its association with... more
Product information "Anti-CEP290"
Protein function: Involved in early and late steps in cilia formation. Its association with CCP110 is required for inhibition of primary cilia formation by CCP110 (PubMed:18694559). May play a role in early ciliogenesis in the disappearance of centriolar satellites and in the transition of primary ciliar vesicles (PCVs) to capped ciliary vesicles (CCVs). Required for the centrosomal recruitment of RAB8A and for the targeting of centriole satellite proteins to centrosomes such as of PCM1 (PubMed:24421332). Required for the correct localization of ciliary and phototransduction proteins in retinal photoreceptor cells, may play a role in ciliary transport processes. Required for efficient recruitment of RAB8A to primary cilium (PubMed:17705300). In the ciliary transition zone is part of the tectonic-like complex which is required for tissue-specific ciliogenesis and may regulate ciliary membrane composition. Involved in regulation of the BBSome complex integrity, specifically for presence of BBS2, BBS5 and BBS8/TTC8 in the complex, and in ciliary targeting of selected BBSome cargos. May play a role in controlling entry of the BBSome complex to cilia possibly implicating IQCB1/NPHP5 (PubMed:25552655). Activates ATF4-mediated transcription (PubMed:16682973). [The UniProt Consortium] Buffer: 40% glycerol and PBS (pH 7.2). 0.02% sodium azide is added as preservative. Highest antigen sequence identity to mouse: 92% and to rat: 91%
| Keywords: | Anti-CT87, Anti-BBS14, Anti-CEP290, Anti-Cep290, Anti-Nephrocystin-6, Anti-Tumor antigen se2-2, Anti-Cancer/testis antigen 87, Anti-Centrosomal protein of 290 kDa, Anti-Bardet-Biedl syndrome 14 protein |
| Supplier: | Atlas Antibodies |
| Supplier-Nr: | HPA043918 |
Properties
| Application: | IHC |
| Antibody Type: | Polyclonal |
| Conjugate: | No |
| Host: | Rabbit |
| Species reactivity: | human |
| Immunogen: | Recombinant Protein Epitope Signature Tag (PrEST) antigen sequence: QVESINKELE ITKEKLHTIE QAWEQETKLG NESSMDKAKK SITNSDIVSI SKKITMLEMK ELNERQRAEH CQKMYEHLRT SLKQMEERNF ELETKFAELT (ATA-APrEST81246) |
Database Information
| KEGG ID : | K16533 | Matching products |
| UniProt ID : | O15078 | Matching products |
| Gene ID : | GeneID 80184 | Matching products |
| Protein Atlas Nr. : | ENSG00000198707 |
Handling & Safety
| Storage: | -20°C |
| Shipping: | +20°C (International: +20°C) |
Caution
Our products are for laboratory research use only: Not for administration to humans!
Our products are for laboratory research use only: Not for administration to humans!
Information about the product reference will follow.
more
You will get a certificate here
Viewed

